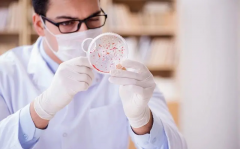
杰特宁试管选性别详细流程，还可筛查胎儿基因缺陷

女性不孕

-
 37岁做试管不算太晚,成功率相对较高
37岁做试管不算太晚,成功率相对较高越来越多的女性在推迟生育,但年龄增长会影响受孕、分娩和胎儿健康。随着现代医学技术的发展,很多女性选择试管来实现生育梦想。但是37岁做试管到底晚不晚呢?下面我们将从科
作者:木易 53 发布时间:2026-04-14 -
 输卵管堵塞怎么办?只能做试管了吗?
输卵管堵塞怎么办?只能做试管了吗?试管是一种辅助生育技术,对于双侧输卵管堵塞的患者来说,是一种治疗不孕不育的有效方法。那么双侧输卵管堵塞做试管多少钱呢?下面就来详细介绍一下。 双侧输卵管堵塞是指女性
作者:木易 107 发布时间:2026-04-14 -
 50岁做试管风险大吗?高龄做试管一定要了解清楚
50岁做试管风险大吗?高龄做试管一定要了解清楚随着现代医学技术的不断发展,越来越多的女性选择通过试管技术来实现自己的生育愿望。但是对于年龄较大的女性来说,这项技术是否安全可靠?本文将从专业角度分析50岁做试管危
作者:木易 92 发布时间:2026-04-14 -
 输卵管结扎后也可以做试管,80%以上可怀孕
输卵管结扎后也可以做试管,80%以上可怀孕输卵管结扎是一种常见的绝育手术,但有时候人们会后悔或者生活发生改变,想要再次怀孕。那么输卵管结扎后还能否通过试管来实现怀孕呢?经过多项研究和医学实践证明,答案是肯定的
作者:木易 71 发布时间:2026-04-14 -
 卵巢早衰女性试管之路:36岁还有机会吗?
卵巢早衰女性试管之路:36岁还有机会吗?卵巢早衰并不是36岁女性实现生育梦想的绝对障碍。通过医院专业的医疗评估、个性化的治疗方案,许多女性仍然可以在试管的道路上找到希望并实现自己的生育梦想。此外,心理支持和健
作者:多米 124 发布时间:2026-04-14 -
 40岁卵巢早衰女性做试管:成功率与挑战!
40岁卵巢早衰女性做试管:成功率与挑战!随着女性年龄的增长,特别是当她们步入40岁这一重要的人生阶段时,卵巢功能往往会逐渐衰退,这种现象被称为卵巢早衰。对于许多渴望拥有自己孩子的女性来说,卵巢早衰无疑是一个巨大的
作者:多米 137 发布时间:2026-04-14 -
杰特宁试管选性别详细流程,还可筛查胎儿基因缺陷
杰特宁试管选性别详细流程,还可筛查胎儿基因缺陷近几年,随着科技的不断发展,消费者对选择婴儿性别的需求也越来越多。杰特宁试管(PGD)被认为是最精确、最可靠的婴儿性别选择技术,它可以在胚胎发育之前准确地鉴定婴儿的性别。 杰特
作者:木易 127 发布时间:2026-04-14 -
 宫颈糜烂有什么症状,对女性健康威胁大
宫颈糜烂有什么症状,对女性健康威胁大宫颈糜烂是妇科疾病中最严重的疾病之一,它可以影响女性的生育能力,甚至对女性的健康造成永久性的损害。那么宫颈糜烂会有什么症状呢? 引起子宫糜烂的原因 宫颈糜烂可能会出现一些症
作者:木易 105 发布时间:2026-04-14 -
 输卵管结扎后的人工授精成功率:一次尝试,高达六成机会拥抱新生命
输卵管结扎后的人工授精成功率:一次尝试,高达六成机会拥抱新生命输卵管结扎是一种治疗不孕不育的复杂手术,它能够帮助许多不孕不育患者最终获得健康的孩子。那么输卵管结扎做人工授精有成功的吗? 输卵管结扎做人工授精成功率高吗? 对于输卵管结扎患
作者:wednesday 77 发布时间:2026-04-14 -
 38岁子宫切除可以做试管吗?成功的几率有多大
38岁子宫切除可以做试管吗?成功的几率有多大在说到女人子宫时,我们应该都知道它对女性有着重要的作用,不仅维持器官的运作,也和生育紧密相关,但在近些年很多女性因为不当的生活方式以及饮食习惯让子宫受损,诱发子宫疾病需
作者:月月 141 发布时间:2026-04-14 -
 42岁选择人授还是三代试管?了解优势后自有答案!
42岁选择人授还是三代试管?了解优势后自有答案!42岁女性在选择人授还是三代试管时,需要根据自己的具体情况和需求进行权衡。如果身体状况良好,只是轻微的不孕不育问题,且预算有限,那么人授可能是一个不错的选择。然而,如果面临
作者:多米 141 发布时间:2026-04-14 -
 引产后可能会发生不孕,一定要做好不孕检查
引产后可能会发生不孕,一定要做好不孕检查引产是一种常见的妇科手术,它可以帮助妇女摆脱不宜繁衍的孕育状况,可以有效降低妇女繁衍的风险。但是引产后不孕可能会发生,因此对于有引产史的妇女来说,了解引产后不孕检查是十
作者:木易 90 发布时间:2026-04-14
